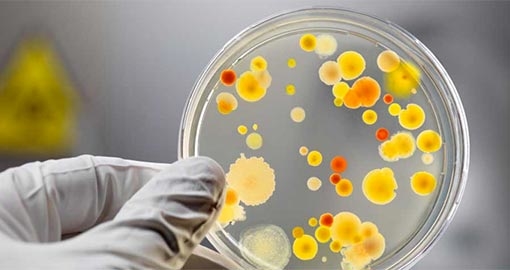
На Тернопільщині – спалах інфекції

У Бучацькому районі Тернопільської області зафіксовано спалах сальмонельозу, люди отруїлися домашніми тортами. Про церозповів лікар-епідеміолог. За попередніми даними, причиною отруєння стала домашня випічка. Загалом у районну лікарню госпіталізували 10 осіб, 3 із них – діти.
У Бучацькому районі Тернопільської області зафіксовано спалах сальмонельозу, люди отруїлися домашніми тортами. Про церозповів лікар-епідеміолог. За попередніми даними, причиною отруєння стала домашня випічка. Загалом у районну лікарню госпіталізували 10 осіб, 3 із них – діти.
Зазначено, що 14-15 червня з ознаками гострої кишкової інфекції за медичною допомогою звернулося четверо жителів селища Золотий Потік.
Протягом вихідних із аналогічними симптомами у Бучацьку районну лікарню було госпіталізовано ще шестеро людей. Усі в стані середньої важкості.
“В області зареєстровано спалах сальмонельозу в побуті. Шестеро з десяти госпіталізовано в інфекційний відділ із попереднім діагнозом “сальмонельоз”, матеріал від хворих відібрано на бактеріологічне дослідження. Попередньо від хворих та контактних виділяється культура “сальмонела”, – розповів лікар-епідеміолог обласного лабораторного центру Держсанепідслужби Світлана Маціпура.
Наразі стан пацієнтів задовільний. Протягом останніх двох днів нових випадків не зареєстровано. Натомість частина хворих уже готується до виписки.
Джерело: Бучацькі новини